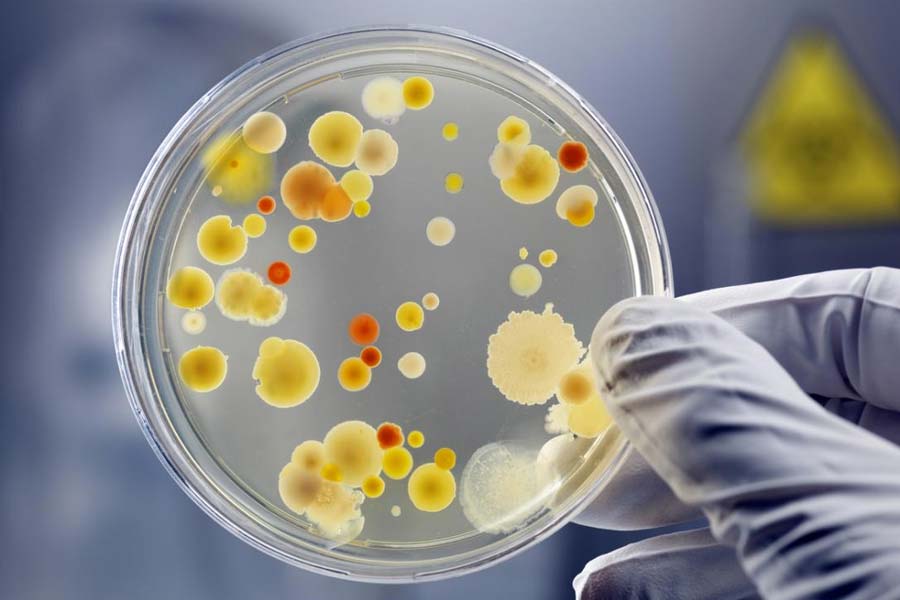
All you need to know about Super Bug and how much it can affect scientists in International Space Station

মহাকাশে বাড়ছে সুপারবাগের চোখরাঙানি! বিপদে পড়তে পারেন মহাকাশচারীরা, কী ভাবে পৌঁছল ওই ব্যাক্টেরিয়া?
প্রাথমিক ভাবে বিজ্ঞানীদের অনুমান, ব্যাকটেরিয়াগুলি মহাকাশেই নিজেদের রূপ পরিবর্তন করে শক্তিশালী হয়ে উঠেছে।


আন্তর্জাতিক মহাকাশ কেন্দ্র (ইন্টারন্যাশনাল স্পেস সেন্টার বা আইএসএস)-এ খুঁজে পাওয়া গিয়েছে নতুন প্রজাতির ব্যাক্টেরিয়া বা ‘সুপারবাগ’। এই সুপারবাগ ভারতীয় বংশোদ্ভূত সুনীতা উইলিয়ামস-সহ বাকি মহাকাশচারীদের স্বাস্থ্যের উপর প্রভাব ফেলতে পারে বলেও আশঙ্কা করা হচ্ছে।


কিন্তু এই ‘সুপারবাগ’ কী? কী ভাবেই বা মহাকাশে পৌঁছল এই ব্যাক্টেরিয়াগুলি?


মহাকাশ গবেষকেরা সম্প্রতি একটি ব্যাক্টেরিয়ার ১৩টি নতুন উপরূপ আবিষ্কার করেছেন মহাকাশে।

প্রাথমিক ভাবে বিজ্ঞানীদের অনুমান, ব্যাক্টেরিয়াগুলি মহাকাশেই নিজেদের রূপ পরিবর্তন করে শক্তিশালী হয়ে উঠেছে।


বিজ্ঞানীরা জানিয়েছেন, যে ব্যাক্টেরিয়াটি নিজের রূপ পরিবর্তন করেছে, তার বৈজ্ঞানিক নাম ‘এন্টারোব্যাক্টর বুগানডেনসিস’।
আরও পড়ুন:


পৃথিবীতে এই ব্যাক্টেরিয়ার যে রূপটি খুঁজে পাওয়া যায়, তা মানুষের শরীরের জন্য ততটা ক্ষতিকারক না হলেও মহাকাশে ওই ব্যাক্টেরিয়া তার রূপ পরিবর্তন করে স্বতন্ত্র হয়ে উঠেছে। ক্ষমতা বৃদ্ধি পেয়েছে সেটির।


বিজ্ঞানীরা মনে করছেন, সুনীতা এবং বাকি মহাকাশচারীরা পৃথিবীতে যে ব্যাক্টেরিয়ারোধী ওষুধ খেয়ে মহাকাশে গিয়েছেন, সেগুলির কোনও প্রভাব ব্যাক্টেরিয়ার এই স্ট্রেনের উপর পড়বে না।


তবে মহাকাশে গিয়ে রূপ বদলিয়ে সুপারবাগে পরিণত হওয়ার পর ব্যাক্টেরিয়াটির ক্ষতি করার ক্ষমতা কতটা বৃদ্ধি পেয়েছে, তা নিয়ে এখনও খুব স্বচ্ছ ধারণা তৈরি হয়নি বিজ্ঞানীদের।


এখনও মহাকাশচারীদের স্বাস্থ্যে এই ব্যাক্টেরিয়ার কোনও প্রভাব পড়েনি বলেও জানা গিয়েছে। তাঁদের নিয়মিত স্বাস্থ্য পরীক্ষার নির্দেশ দেওয়া হয়েছে।
আরও পড়ুন:


বিজ্ঞানীরা জানিয়েছেন, ‘এন্টারোব্যাক্টর বুগানডেনসিস’ ব্যাক্টেরিয়া মূলত মানুষের অন্ত্রে বাস করে। এ ছাড়া শরীরের অন্য জায়গাতেও এই ব্যাক্টেরিয়ার খোঁজ মিলতে পারে। মানুষের মাধ্যমেই এই ব্যাক্টেরিয়া মহাকাশে পৌঁছেছে বলেও জানিয়েছেন বিজ্ঞানীরা।


শরীরে থাকলেও এই ব্যাক্টেরিয়া সাধারণত কোনও মানুষের ক্ষতি করে না।


তবে যাঁদের অনাক্রম্যতা (ইমিউনিটি) কম, তাঁদের শরীরের ক্ষতি করতে পারে এই ব্যাক্টেরিয়া। দুর্বল অনাক্রম্যতাকে আরও দুর্বল করে দিতে পারে।


মহাকাশ বিজ্ঞানীদের দাবি, মহাকাশে এই ব্যাক্টেরিয়ার রূপ বদলানোর ক্ষমতা এবং সংক্রমণের ক্ষমতা অনেক বেশি।


মহাকাশে এরা রূপ বদলে এতটাই ক্ষমতাশালী হয়ে যায় যে, সাধারণ ওষুধের খুব একটা প্রভাব এদের উপর পড়ে না।


চিকিৎসার গবেষণাপত্র ‘মাইক্রোবায়োম’-এর গবেষকদের মতে, মহাকাশে ব্যাক্টেরিয়াটির ১৩টি উপরূপের উপর ওষুধের কোনও প্রভাব পড়ে না বলে পরীক্ষা করে দেখা গিয়েছে। ফলে আন্তর্জাতিক মহাকাশ কেন্দ্রে থাকা মহাকাশচারীদের অসুস্থতার সম্ভাবনা এখনই উড়িয়ে দিচ্ছেন না বিজ্ঞানীরা।


কেউ কেউ আবার মনে করছেন, এই ব্যাক্টেরিয়া পরীক্ষা করে মহাকাশে রোগজীবাণু, অসুস্থতা এবং চিকিৎসা বিজ্ঞান সংক্রান্ত একটা নতুন দিক খুলে যেতে পারে।


তবে ব্যাক্টেরিয়ার নতুন রূপ বিজ্ঞানীদের সঙ্গে পৃথিবীতে ফিরে আসার পর কোনও মহামারি বা অতিমারি হওয়ার সম্ভাবনা রয়েছে কি না, সে দিকেও নজর রাখছেন বিজ্ঞানীরা।







